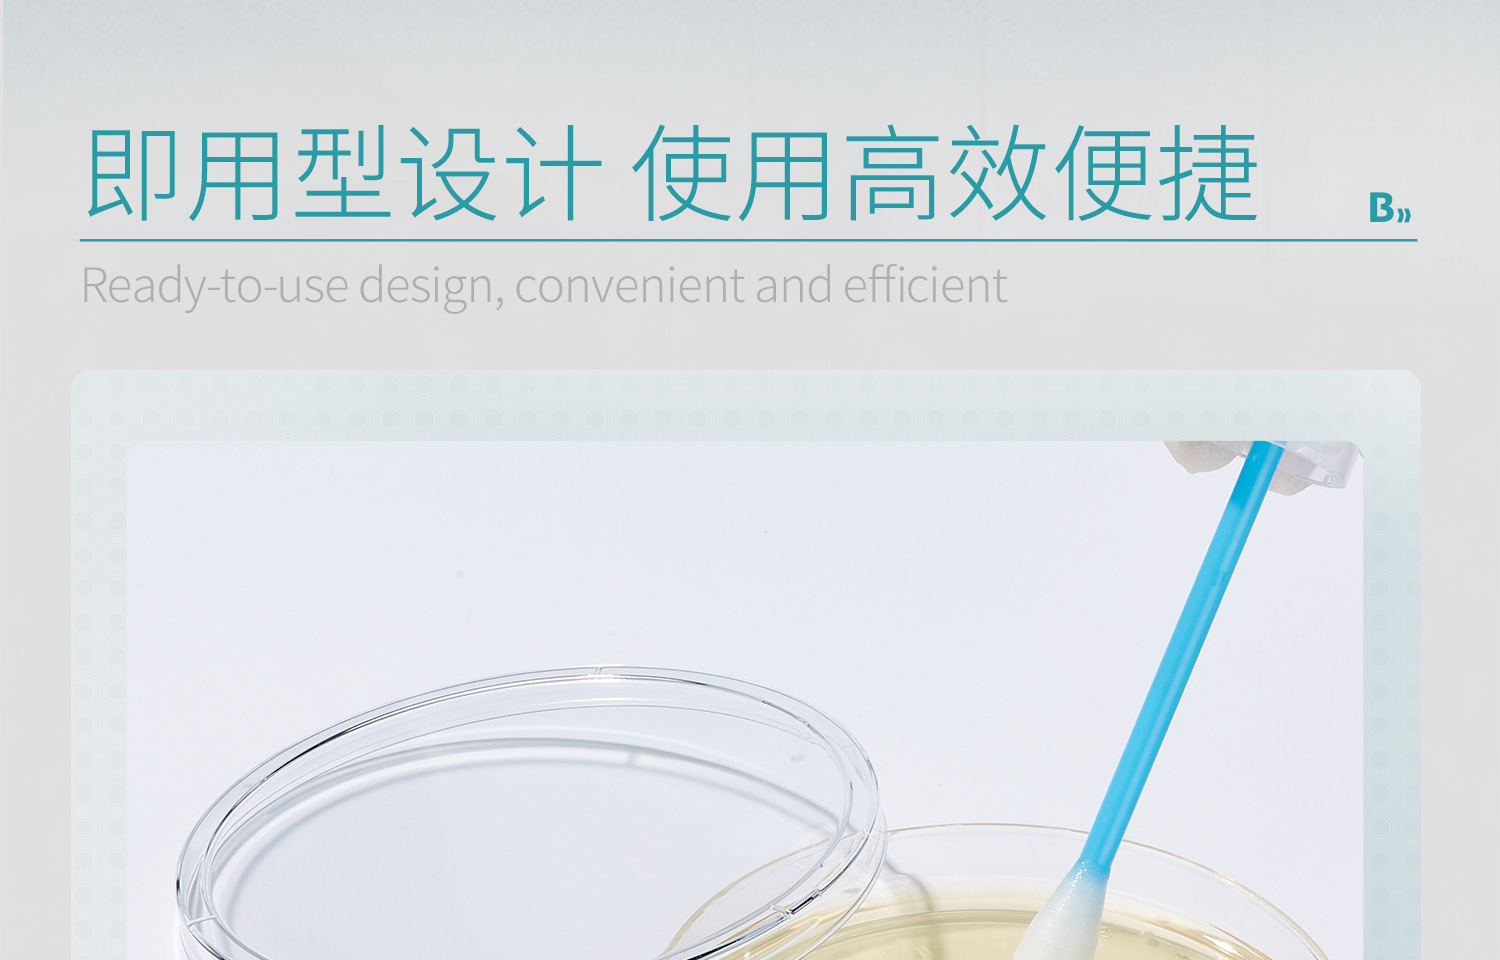

Биопитательный агар Бикмана Планшетный агар-агар LB-среда для культивирования BHI бактерии TCBS-агар-среда для культивирования
Продано за 30 дней:
235 шт.
Всего продаж:
9249 шт.
Минимальное количество для заказа:
1 шт.
Биопитательный агар Бикмана Планшетный агар-агар LB-среда для культивирования BHI бактерии TCBS-агар-среда для культивирования
от 67.47 ₽ за 1 шт.
-21%
67.47 ₽
Доставка по Китаю включена в цену
Оптом
от 1 шт.
53.13 ₽
от 1 шт.
67.47 ₽
Описание

Характеристики
Происхождение:
Хунань
Модель:
9cm
Импортировать ли:
нет
сортировать:
диагностические реагенты
номер товара:
1580
уровень:
другой
Технические характеристики продукта:
10 шт./упак.
бренд:
пикман
Область использования:
Для определения общего количества бактерий
Название продукта:
Пластина с питательным агаром
Это опасный химикат?:
нет
Спецификация:
Питательная агаровая чашка 9 см, 1 штука [индивидуальная упаковка] 110704024; Питательная агаровая чашка 9 см, 1 шт./пакет, 2 шт. [индивидуальная упаковка] 110704024-2; Питательные агаровые чашки 9 см, 10 штук в индивидуальной упаковке [в комплекте с инокуляционной петлей] 110704024-10HC; Питательная агаровая чашка 9 см, 10 штук в упаковке, трехслойная стерильная упаковка [бесплатная инокуляционная петля] 110704014-HC; Агаровая чашка TCBS, 6 см, 1 штука [индивидуальная упаковка] 110704028; Агаровая чашка TCBS 6 см, 10 штук/упаковка [двухслойная стерильная упаковка] 110704029; Агаровая чашка TCBS 6 см + расходные материалы 1 шт. [индивидуальная упаковка] 110704028-H; Агаровая чашка TCBS 6 см + расходные материалы, 10 шт./упаковка [двухслойная стерильная упаковка] 110704029-H; Агаровая чашка TCBS 9 см, 5 шт./упак. [двухслойная стерильная упаковка] 110704030; Агаровая чашка TCBS, 9 см, 1 штука [индивидуальная упаковка] 110704017; Агаровая чашка TCBS 9 см + расходные материалы 1 шт. [индивидуальная упаковка] 110704017-H; Агаровая пластина TSA 9 см, 10 шт./упак. [трехслойная стерильная упаковка] 110704032; Пластина для контакта с поверхностью TSA, 55 мм, изогнутое дно, 10 шт./упаковка [трехслойная стерильная упаковка] 110704034; Агаровая пластина BHI 9см 10шт/упак. [трехслойная стерильная упаковка] 110704026; Агаровая чашка R2A, 9 см, 10 штук/упаковка [трехслойная стерильная упаковка] 110704031; Планшет агаровой среды 7 см, 10 штук/упаковка [трехслойная стерильная упаковка] 110704010; Планшет агаровой среды 9 см, 10 штук/упаковка [трехслойная стерильная упаковка] 110704011; Агаровая чашка ЛБ 9 см, 10 шт./упак. [трехслойная стерильная упаковка] 110704002; Агаровая чашка LB, 9 см (с устойчивостью к ампициллину), 10 штук в упаковке [двухслойная стерильная упаковка] 110704047; Агаровая чашка LB, 9 см (с устойчивостью к канамикину), 10 штук в упаковке [двухслойная стерильная упаковка] 110704046; Агаровая чашка LB, 9 см (с устойчивостью к ампициллину), 50 штук/5 упаковок [двухслойная стерильная упаковка] 110704047-5; Агаровая чашка LB, 9 см (с устойчивостью к канамикину), 50 штук/5 упаковок [двухслойная стерильная упаковка] 110704046-5; Таблетка McConkey 9см 10шт/упак [трехслойная стерильная упаковка] 110704035; Эритросин и агар блестящего синего цвета, 9 см, 10 штук в упаковке [трехслойная стерильная упаковка] 110704037; Шоколадная агаровая пластина 9 см, 10 штук/упаковка [трехслойная стерильная упаковка] 110704018; Агаровая чашка Берда-Паркера 9 см, 10 шт./упак. [трехслойная стерильная упаковка] 110704040; Агаровая чашка СС, 9 см, 10 шт./упак. [трехслойная стерильная упаковка] 110704006; Агаровая чашка с сахарным агаром Сабурода, 9 см, 10 шт./упаковка [Трехслойная стерильная упаковка] 110704039; Агаровая чашка МАГ (9 см), 10 штук в упаковке [трёхслойная стерильная упаковка] [срок годности 9 месяцев] 110704003; Лабораторная питательная агаровая чашка Labshark, 9 см, 10 штук в упаковке [двухслойная стерильная упаковка] 131001001-H; Лабораторная питательная агаровая чашка Labshark, 9 см, 1 штука [индивидуальная упаковка] 131001002; Лабораторная питательная агаровая чашка Labshark, 9 см, 50 штук/5 упаковок [двухслойная стерильная упаковка] 131001001-5H; Лабораторная питательная агаровая чашка Labshark, 9 см, 100 штук/10 упаковок [двухслойная стерильная упаковка] 131001001-10; Лабораторная питательная агаровая чашка Labshark, 9 см, 200 штук/20 упаковок [двухслойная стерильная упаковка] 131001001-20; Пластина для питательного агар Labshark, 9 см, 300 штук/30 упаковок [двухслойная стерильная упаковка] 131001001-30; Лабораторная питательная агаровая чашка Labshark, 9 см, 400 штук/40 упаковок [двухслойная стерильная упаковка] 131001001-40; Labshark Nutritional Qiong 9 см таблетки для похудения, 500 штук/50 упаковок [двухслойная стерильная упаковка] 131001001-50; Агаровая чашка Labshark SS, 9 см, 10 шт./упаковка [двухслойная стерильная упаковка] 131001011; Агаровые чашки с сахарным агаром Labshark Sabouraud, 9 см, 10 штук в упаковке [Двухслойная стерильная упаковка] 131001012; Агаровая чашка Labshark MH, 9 см, 10 шт./упаковка [двухслойная стерильная упаковка] 131001013
О продавце
Имя:
Оценка предложения:
4.0
Оценка сервиса:
5.0
Оценка споров и жалоб:
5.0
repeatPurchasePercent:
0.520763837516389
Оценка логистики:
4.4
qualityRefundWithin30Day:
0.000777302759424796
afterSalesExperienceScore:
4.3
Оценка консультации:
4.0
collect30DayWithin48HPercent:
1.0

Биопитательный агар Бикмана Планшетный агар-агар LB-среда для культивирования BHI бактерии TCBS-агар-среда для культивирования
53.13 ₽
53.13 ₽




 Курс юаня: 12.5
Курс юаня: 12.5



